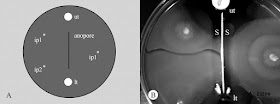

Las copas de los árboles no están entrelazadas entre si sino que forman un espacio en el que apenas se tocan
Si los individuos tienen que estar diferenciados para poder seleccionados, parece como si los colectivos también tuviesen mecanismos para no mezclarse, para individualizarse creando fronteras. Las bacterias parecen que han sido también precursoras en el establecimiento de fronteras.
Proteus, la bacteria creadora de fronteras
Dienes en 1946. La
frontera es real, las células de una cepa respetan la frontera y no
invaden el territorio de la otra cepa, de hecho la frontera es una
brecha entre ambas colonias, como si fuera un valle.Cuando los investigadores introdujeron una membrana que impedía el contacto físico entre estas cepas no se producía la frontera. La membrana dejaba pasar hormonas o toxinas, pero por lo visto Proteus mirabilis no agrede con toxinas a la cepa distinta. Lo que parece es que la reconoce.
Gibbs y Greenberg publicaron en 2008 un artículo en Science en el que
descubren unos genes responsables. Cuando quitan estos genes Proteus no
crea frontera, y cuando se los vuelven a meter Proteus vuelve a crear
frontera. El trabajo no es técnicamente novedoso, pero que unos genes
controlen algo tan "intangible" como la capacidad para formar una
frontera es alucinante y abre y expande el campo de la sociobiología en bacterias. Podéis escuchar el podcast sobre esta noticia aquí.
Cuando no se tiene nada que defender mejor no tener fronteras
Es el caso de los gallegos, un pueblo con una cultura distinta que no encaja en la cultura mayoritaria castellana y que vio en el siglo XIX como se priorizaban económicamente otras zonas de España y al que no le quedó otra opción que la emigración para mejorar sus condiciones de vida.
 |
| Rafael Dieste (Rianxo 1899, Compostela 1981) definió de esta manera "sui generis" y romántica la diáspora gallega. Según el autor, en Galicia no se emigra por falta de oportunidades económicas, sino que emigramos porque Galicia no tiene confines determinados |
Crear fronteras para mantener privilegios
En el siguiente video, a partir del minuto 16:24, el profesor de política de la Universidad Complutense de Madrid, Jorge Verstrynge, aclara en la entrevista que cree que si los obreros tienen patria
En España, antes de la expulsión de musulmanes y judíos había una pugna entre los bloques cristiano y musulmán. La nobleza cristiana, de origen germánico y naturalizada durante siglos, tenía en mente la reconquista de los antiguos territorios que finalmente consiguen con la toma de Granada en 1492. A partir de entonces se establece un sistema de castas. Ya no solo había una división entre la nobleza de origen germánico y el pueblo, antiguos ciudadanos hispano-romanos convertidos al cristianismo, ahora, existían cristianos nuevos, moriscos, judíos. Para distinguir a los ganadores, los cristianos viejos, se estableció la costumbre de dar dos apellidos, uno del padre y otro de la madre. De esta manera, los cristianos viejos podían distinguir a aquellos que no lo eran por sus apellidos y exigir sus privilegios. Esta mentalidad de castas se exportó a las Américas y se plasmó en una pigmentocracia que continúa hasta nuestros días: cuanto más blanco mejor eres.
 |
| Cuadros de castas del Museo de las Américas en Madrid. Dice así: de español e india produce mestizo. En la fotografía se ve como el español tiene un 1, la india 2 y el niño mestizo un 3. |
La ciencia se utilizó para los mismos fines en la Alemania nazi. Produce escalofríos ver los árboles genealógicos utilizados para discriminar ciudadanos
 |
| Merece la pena entrar en el enlace y comprobar quién era considerado alemán según estas leyes racistas según el porcentaje de sangre aria que tuviesen. Fuente |
¿Son las fronteras una unidad de egoísmo?
Lo mismo que los ribozimas de hace 4500 millones de años necesitaron diferenciarse en las capas de filosilicatos del barro, o posteriormente en las cápsides de los protovirus, o en el interior de las membranas plasmáticas de las arqueobacterias para poder ser seleccionados, quizás, y esto es lo más interesante de la investigación biológica actual, las fronteras sean la membrana que separa el interior del exterior de la célula social, la frontera entre nosotros y ellos.
Quienes saben mucho de esto son los gurús de sectas destructivas. Un gurú es un artífice de fronteras de grupo. Uno de los mecanismos básicos, y son entre 5 y 7, no más, para crear una secta, es crear la figura de un enemigo exterior, el diablo por ejemplo, y mantener siempre juntos a los integrantes de la secta. Este tipo de frontera de grupo que los mantiene alejados de sus antiguas fronteras, lease familias, unido a otros mecanismos de control mental, consiguen en un tiempo record alienar la individualidad de sus integrantes.
Una madre divorciada que hace alienación parenteral con sus hijos está creando una frontera entre su nuevo hogar, si es que se ha vuelto a casar, y su exmarido. La alienación parenteral no es casual, es un intento de poner unos nuevos límites y excluir de esos límites al padre de los niños.
Para saber más:
https://www.ncbi.nlm.nih.gov/pmc/articles/PMC3024916/
J Bacteriol. 2009 Jun;191(12):3892-900. 2009 Feb 27.The Dienes phenomenon: competition and territoriality in Swarming Proteus mirabilis. Budding AE, Ingham CJ, Bitter W, Vandenbroucke-Grauls CM, Schneeberger PM.
Gibbs KA, Greenberg EP. Territoriality in Proteus: advertisement and aggression. Chemical reviews. 2011;(1520-6890):188-94.

No hay comentarios:
Publicar un comentario
Cada vez que lees un artículo y no dejas un comentario, alguien mata a un gatito en alguna parte del mundo...